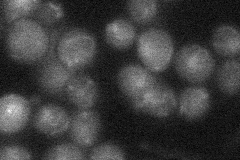

View description
Protein that acts with Mms1p in a repair pathway that may be involved in resolving replication intermediates or preventing the damage caused by blocked replication forks; required for accurate meiotic chromosome segregation
Localization:
Intensity:
Fold change:
Significance:
-
C’ GFP library in SD

punctate:bud neckN/A -
N' NOP1pr-GFP in SD

punctate,nucleus41.3351 -
N' TEF2pr-mCherry in SD

punctate,nucleus31.0454 -
N' NATIVEpr-GFP in SD
below threshold18.5866 -
N' TEF2pr-VC and Cyto-VN in SD

#N/A0 -
C’ GFP library in SD+DTT

punctate.bud neck17.81.03No -
C’ GFP library in SD+H2O2

punctate.bud neck21.841.26No -
C’ GFP library in Starvation Media

punctate,bud neck16.280.94No -
C’ GFP library on the background of Pup2-DaMP

punctate:bud neck -
C’ GFP library on the background of CCT mutant

punctate:bud neck19.36421.12477No
